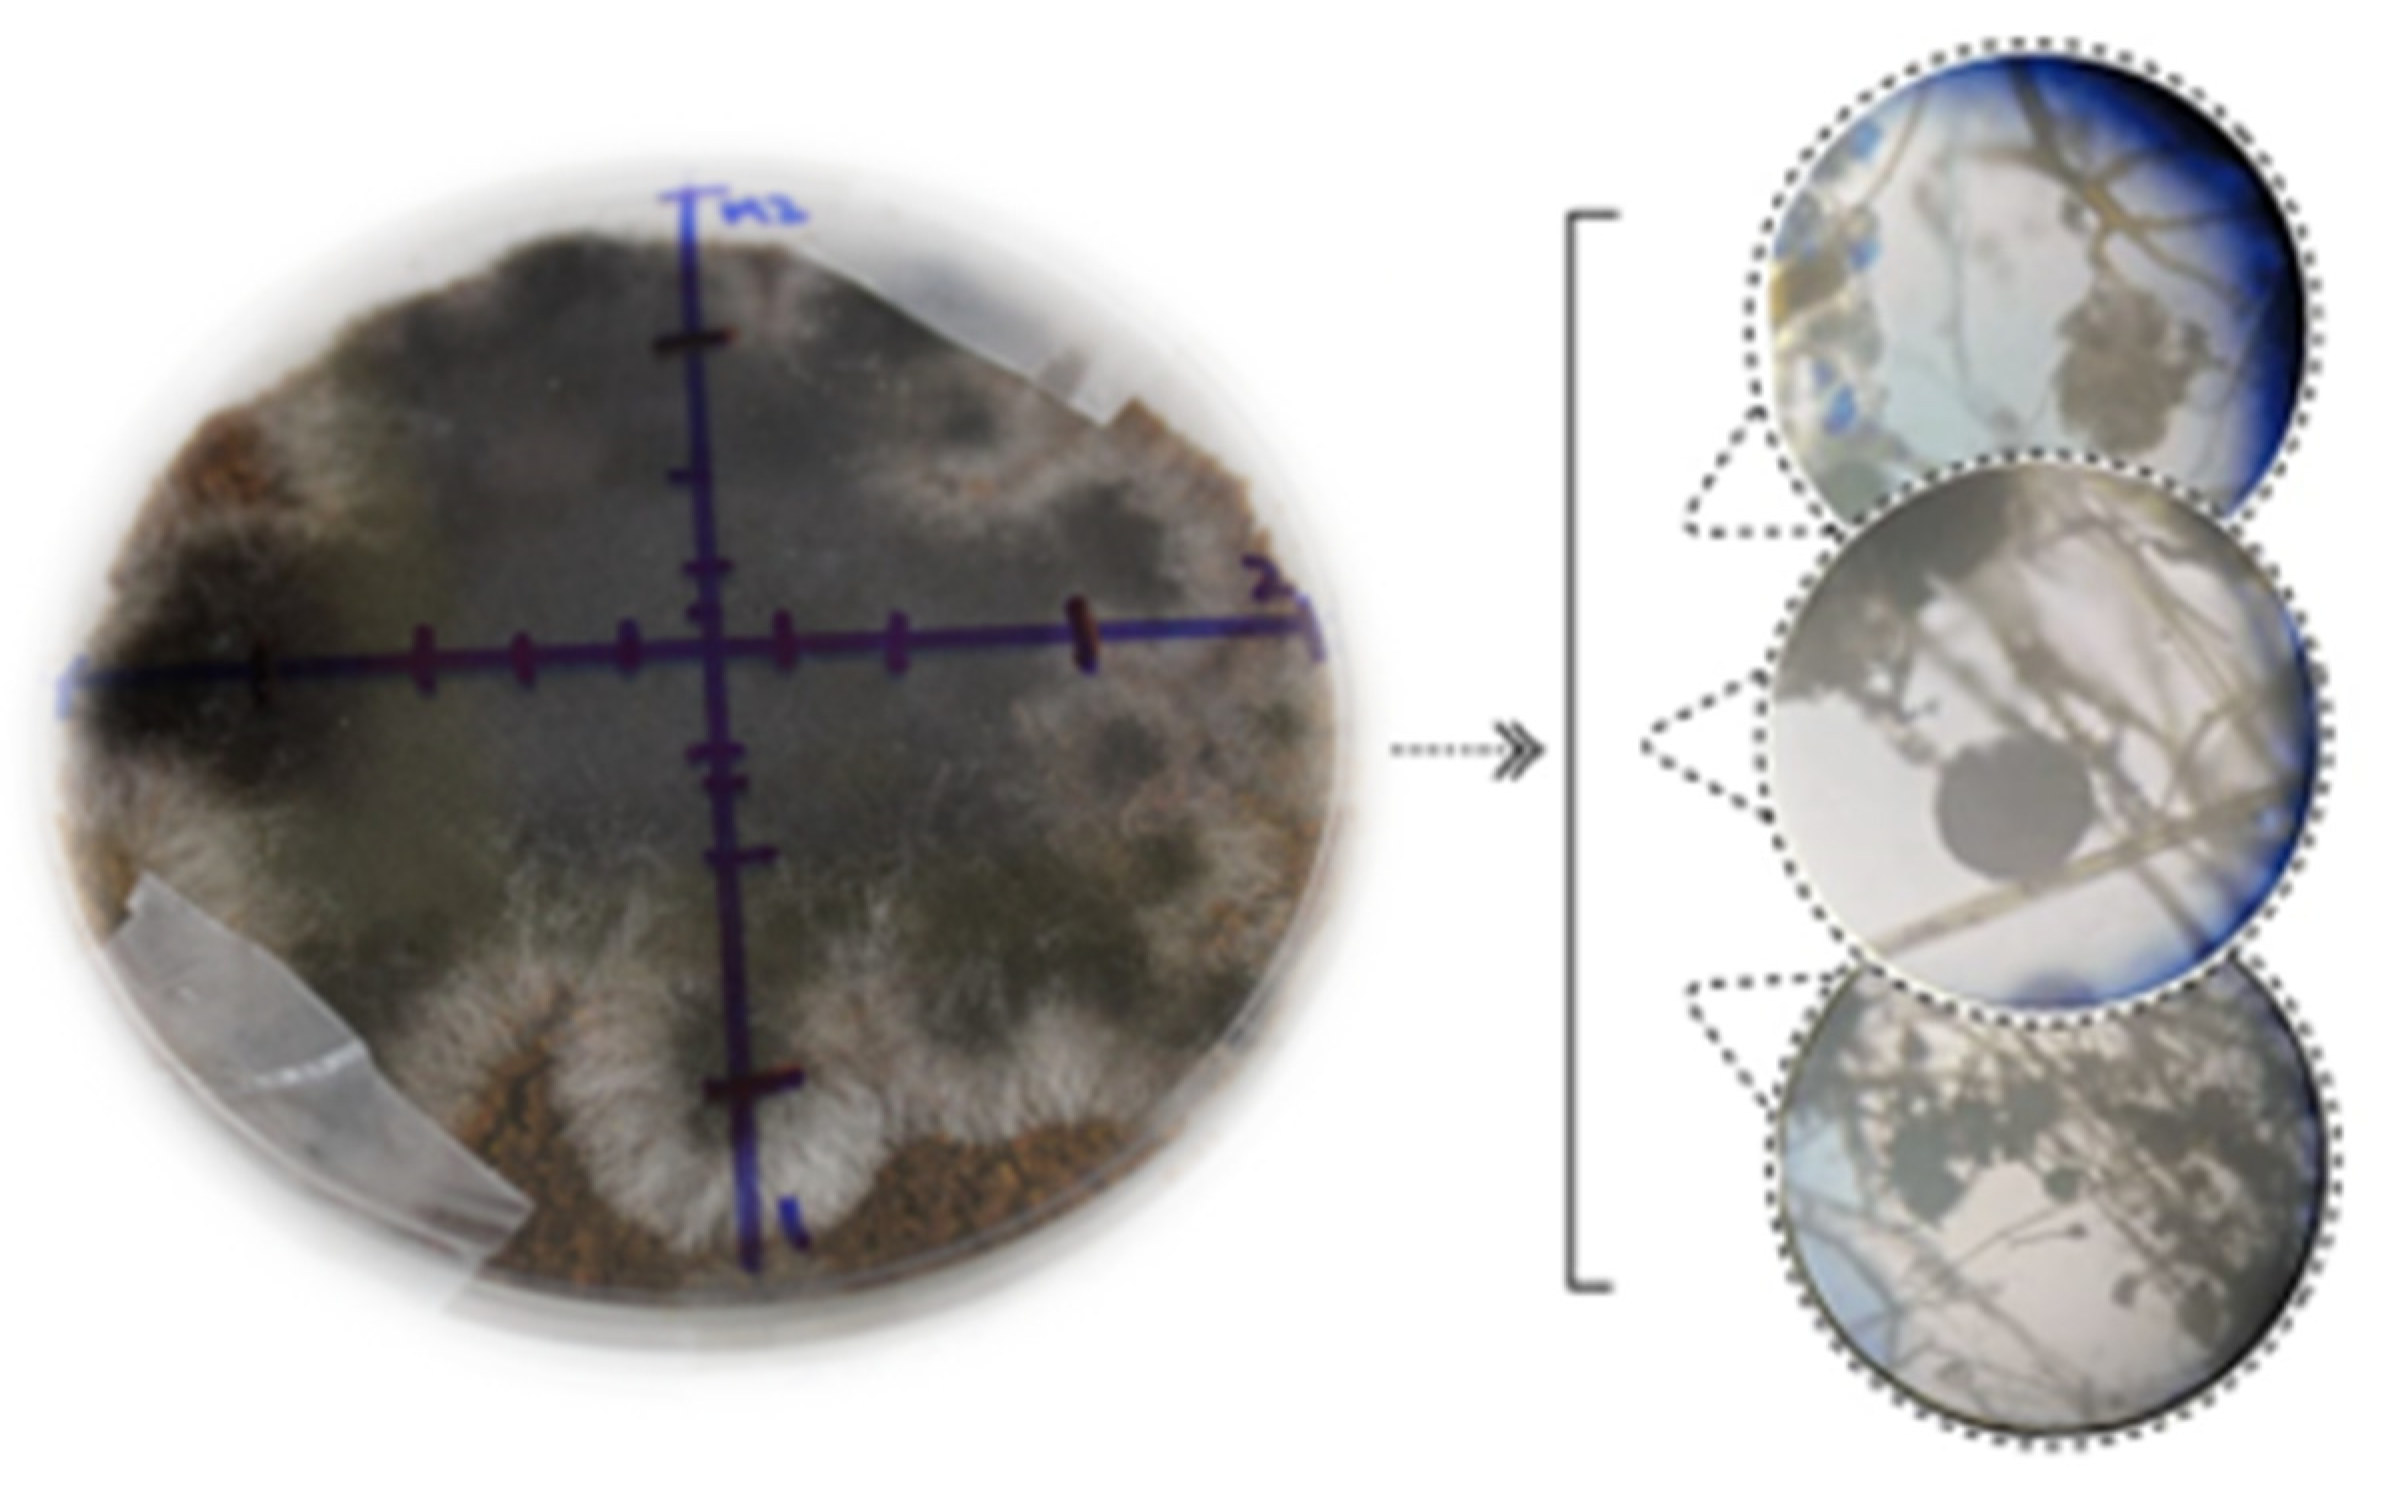

Dual Emerging Applications of Solid-State Fermentation (SSF) with Aspergillus niger and Ultrasonic-Assisted Extraction (UAE) for the Obtention of Antimicrobial Polyphenols from Pineapple Waste
Abstract
1. Introduction
2. Materials and Methods
2.1. Reagents
2.2. Microorganisms
2.3. Obtaining the Fermented Material
2.3.1. Tests of Support in Solid-State Fermentation
2.3.2. Solid-State Fermentation
2.4. Extraction of Phenolic Compounds
2.5. Preliminary Analysis of Extraction of Bioactive Compounds
2.6. Box–Behnken Design
2.7. Total Phenolic Content (TPC)
2.7.1. Identification of Compounds Using RP-HPLC-ESI-MS
2.8. Antimicrobial Activity
2.8.1. Determination of Minimum Inhibitory Concentration (MIC)
2.8.2. Bacterial Growth Curve
2.8.3. Observation with a Transmission Electron Microscope (TEM)
2.9. Statistical Analysis
3. Results
3.1. Solid-State Fermentation
3.2. Preliminary Analyses for Optimization
3.2.1. Solid–Liquid Ratio X1
3.2.2. Ethanol Concentration (X2)
3.2.3. Extraction Cycle (X3)
3.3. Box–Behnken Design
3.4. Model Verification
3.5. Compounds Present in the Optimized Extract
3.6. Antimicrobial Activity
3.6.1. Determination of Minimum Inhibitory Concentration (MIC)
3.6.2. Bacterial Growth Curve
3.6.3. Observation with a Transmission Electron Microscope (TEM)
4. Discussion
4.1. Solid-State Fermentation
4.2. Preliminary Analysis for Optimization
4.3. Optimization: Box–Behnken Design
4.4. Antimicrobial Activity
5. Conclusions
Author Contributions
Funding
Institutional Review Board Statement
Informed Consent Statement
Data Availability Statement
Acknowledgments
Conflicts of Interest
References
- Rico, X.; Gullón, B.; Alonso, J.L.; Yáñez, R. Recovery of high value-added compounds from pineapple, melon, watermelon and pumpkin processing by-products: An overview. Food Res. Int. 2020, 132, 109086. [Google Scholar] [CrossRef] [PubMed]
- Qdais, A.H.; Abdulla, F.; Qrenawi, L. Solid Waste Landfills as a Source of Green Energy: Case Study of Al Akeeder Landfill. Jordan J. Mech. Ind. Eng. 2010, 4, 69–74. [Google Scholar]
- Rashad, M.M.; Mahmoud, A.E.; Ali, M.M.; Nooman, M.U.; Al-Kashef, A.S. Antioxidant and anticancer agents produced from pineapple waste by solid state fermentation. Int. J. Toxicol. Pharmacol. 2015, 7, 287–296. [Google Scholar]
- Aruna, T.E. Production of value-added product from pineapple peels using solid state fermentation. Innov. Food Sci. Emerg. Technol. 2019, 57, 102193. [Google Scholar] [CrossRef]
- Vega-Castro, O.; Contreras-Calderon, J.; León, E.; Segura, A.; Arias, M.; Pérez, L.; Sobral, P.J. Characterization of a polyhydroxyalkanoate obtained from pineapple peel waste using Ralsthonia eutropha. J. Biotechnol. 2016, 231, 232–238. [Google Scholar] [CrossRef]
- Brito, T.B.N.; Lima, L.R.; Santos, M.B.; Moreira, R.A.; Cameron, L.; Fai, A.C.; Ferreira, M.S. Antimicrobial, antioxidant, volatile and phenolic profiles of cabbage-stalk and pineapple-crown flour revealed by GC-MS and UPLC-MSE. Food Chem. 2021, 339, 127882. [Google Scholar] [CrossRef] [PubMed]
- Acosta-Estrada, B.A.; Gutiérrez-Uribe, J.A.; Serna-Saldívar, S.O. Bound phenolics in foods, a review. Food Chem. 2014, 152, 46–55. [Google Scholar] [CrossRef]
- Lourenço, S.C.; Campos, D.A.; Gómez-García, R.; Pintado, M.; Oliveira, M.C.; Santos, D.I.; Corrêa-Filho, L.C.; Moldão-Martins, M.; Alves, V.D. Optimization of natural antioxidants extraction from pineapple peel and their stabilization by spray drying. Foods 2021, 10, 1255. [Google Scholar] [CrossRef]
- Safdar, M.N.; Kausar, T.; Jabbar, S.; Mumtaz, A.; Ahad, K.; Saddozai, A.A. Extraction and quantification of polyphenols from kinnow (Citrus reticulate L.) peel using ultrasound and maceration techniques. J. Food Drug Anal. 2017, 25, 488–500. [Google Scholar] [CrossRef]
- Luque-Garcia, J.; de Castro, M.L. Ultrasound: A powerful tool for leaching. TrAC Trends Anal. Chem. 2003, 22, 41–47. [Google Scholar] [CrossRef]
- Wang, Z.; Ahmad, W.; Zhu, A.; Geng, W.; Kang, W.; Ouyang, Q.; Chen, Q. Ultrasonics Sonochemistry Identification of volatile compounds and metabolic pathway during ultrasound-assisted kombucha fermentation by HS-SPME-GC/MS combined with metabolomic analysis. Ultrason. Sonochem. 2023, 94, 106339. [Google Scholar] [CrossRef] [PubMed]
- Paz-Arteaga, S.L.; Ascacio-Valdés, J.A.; Aguilar, C.N.; Cadena-Chamorro, E.; Serna-Cock, L.; Aguilar-González, M.A.; Ramírez-Guzmán, N.; Torres-León, C. Bioprocessing of pineapple waste for sustainable production of bioactive compounds using solid-state fermentation. Innov. Food Sci. Emerg. Technol. 2023, 85, 103313. [Google Scholar] [CrossRef]
- Salman, S.; Öz, G.; Felek, R.; Haznedar, A.; Turna, T.; Özdemir, F. Effects of fermentation time on phenolic composition, antioxidant and antimicrobial activities of green, oolong, and black teas. Food Biosci. 2022, 49, 101884. [Google Scholar] [CrossRef]
- Molyneux, P. The Use of The Stable Free Radical Diphenylpicryl-Hydrazyl (DPPH) for Estimating Anti-Oxidant Activity. Songklanakarin J. Sci. Technol. 2004, 26, 211–219. [Google Scholar]
- Ascacio-Valdés, J.A.; Aguilera-Carbó, A.F.; Buenrostro, J.J.; Prado-Barragán, A.; Rodríguez-Herrera, R.; Aguilar, C.N. The complete biodegradation pathway of ellagitannins by Aspergillus niger in solid-state fermentation. J. Basic Microbiol. 2016, 56, 329–336. [Google Scholar] [CrossRef]
- Torres-León, C.; de Azevedo Ramos, B.; dos Santos Correia, M.T.; Carneiro-da-Cunha, M.G.; Ramirez-Guzman, N.; Alves, L.C.; Brayner, F.A.; Ascacio-Valdes, J.; Álvarez-Pérez, O.B.; Aguilar, C.N. Antioxidant and anti-staphylococcal activity of polyphenolic-rich extracts from Ataulfo mango seed. LWT 2021, 148, 111653. [Google Scholar] [CrossRef]
- Babii, C.; Bahrin, L.G.; Neagu, A.; Gostin, I.; Mihasan, M.; Birsa, L.M.; Stefan, M. Antibacterial activity and proposed action mechanism of a new class of synthetic tricyclic flavonoids. J. Appl. Microbiol. 2016, 120, 630–637. [Google Scholar] [CrossRef]
- Zeng, W.; He, Q.; Sun, Q.; Zhong, K.; Gao, H. International Journal of Food Microbiology Antibacterial activity of water-soluble extract from pine needles of Cedrus deodara. Int. J. Food Microbiol. 2012, 153, 78–84. [Google Scholar] [CrossRef]
- Pandey, A.; Soccol, C.R.; Mitchell, D. Pre-treatment of agro-industrial residues. In Biotechnology for Agro-Industrial Residues Utilisation: Utilisation of Agro-Residues; Springer: Cham, Switzerland, 2009; pp. 13–33. [Google Scholar]
- Buenrostro-Figueroa, J.J.; Velázquez, M.; Flores-Ortega, O.; Ascacio-Valdes, J.A.; Huerta-Ochoa, S.; Aguilar, C.N.; Prado-Barragán, L. Solid state fermentation of fig (Ficus carica L.) by-products using fungi to obtain phenolic compounds with antioxidant activity and qualitative evaluation of phenolics obtained. Process. Biochem. 2017, 62, 16–23. [Google Scholar] [CrossRef]
- Torres-León, C.; Ramírez-Guzman, N.; Ascacio-Valdes, J.; Serna-Cock, L.; dos Santos Correia, M.T.; Contre-ras-Esquivel, J.C.; Aguilar, C.N. Solid-state fermentation with Aspergillus niger to enhance the phenolic contents and antioxidative activity of Mexican mango seed: A promising source of natural antioxidants. LWT 2019, 112, 108236. [Google Scholar] [CrossRef]
- De Oliveira, A.C.; Valentim, I.B.; Silva, C.A.; Bechara, E.J.H.; de Barros, M.P.; Mano, C.M.; Goulart, M.O.F. Total phenolic content and free radical scavenging activities of methanolic extract powders of tropical fruit residues. Food Chem. 2009, 115, 469–475. [Google Scholar] [CrossRef]
- Torres-León, C.; Rojas, R.; Serna-Cock, L.; Belmares-Cerda, R.; Aguilar, C.N. Extraction of antioxidants from mango seed kernel: Optimization assisted by microwave. Food Bioprod. Process. 2017, 105, 188–196. [Google Scholar] [CrossRef]
- Venkateswara, M.; Singh, A.; Sunil, C.K.; Rawson, A. Trends in Food Science & Technology Ultrasonication—A green technology extraction technique for spices: A review. Trends Food Sci. Technol. 2021, 116, 975–991. [Google Scholar]
- Selahvarzi, A.; Ramezan, Y.; Reza, M.; Namdar, B. Food Bioscience Optimization of ultrasonic-assisted extraction of phenolic compounds from pomegranate and orange peels and their antioxidant activity in a functional drink. Food Biosci. 2022, 49, 101918. [Google Scholar] [CrossRef]
- Rasheed, A.; Cobham, E.; Zeighami, M.; Ong, S. Extraction of phenolic compounds from pineapple fruit. In Proceedings of the 2nd International Symposium on Processing & Drying of Foods, Vegetables and Fruits (ISPDFVF 2012), Semenyih, Malaysia, 18–19 June 2012. [Google Scholar]
- M’hiri, N.; Ioannou, I.; Ghoul, M.; Boudhrioua, N.M. Extraction Methods of Citrus Peel Phenolic Compounds. Food Rev. 2014, 30, 265–290. [Google Scholar] [CrossRef]
- Brahmi, F.; Blando, F.; Sellami, R.; Mehdi, S.; De Bellis, L.; Negro, C.; Haddadi-Guemghar, H.; Madani, K.; Makhlouf-Boulekbache, L. Optimization of the conditions for ultrasound-assisted extraction of phenolic compounds from Opuntia ficus-indica [L.] Mill. flowers and comparison with conventional procedures. Ind. Crops Prod. 2022, 184, 114977. [Google Scholar] [CrossRef]
- Garmus, T.T.; Paviani, L.C.; Queiroga, C.L.; Cabral, F.A. Extraction of phenolic compounds from pepper-rosmarin (Lippia sidoides Cham.) leaves by sequential extraction in fixed bed extractor using supercritical CO2, ethanol and water as solvents. J. Supercrit. Fluids 2015, 99, 68–75. [Google Scholar] [CrossRef]
- Pérez-Jiménez, J.; Arranz, S.; Tabernero, M.; Díaz-Rubio, M.E.; Serrano, J.; Goñi, I.; Saura-Calixto, F. Updated methodology to determine antioxidant capacity in plant foods, oils and beverages: Extraction, measurement and expression of results. Food Res. Int. 2008, 41, 274–285. [Google Scholar] [CrossRef]
- Ozsefil, I.C.; Ziylan-yavas, A. Green approach for polyphenol extraction from waste tea biomass: Single and hybrid application of conventional and ultrasound-assisted extraction. Environ. Res. 2023, 235, 116703. [Google Scholar] [CrossRef] [PubMed]
- Sepúlveda, L.; Romaní, A.; Aguilar, C.N.; Teixeira, J. Valorization of pineapple waste for the extraction of bioactive compounds and glycosides using autohydrolysis. Innov. Food Sci. Emerg. Technol. 2018, 47, 38–45. [Google Scholar] [CrossRef]
- Harith, N.S.; Rahman, N.A.; Zamanhuri, N.A.; Hashib, S.A. Materials Today: Proceedings Microwave-based antioxidant extraction from pineapple peel waste. Mater. Today Proc. 2023. [Google Scholar] [CrossRef]
- Mushtaq, M.; Sultana, B.; Anwar, F.; Adnan, A.; Rizvi, S.S.H. The Journal of Supercritical Fluids Enzyme-assisted supercritical fluid extraction of phenolic antioxidants from pomegranate peel. J. Supercrit. Fluids 2015, 104, 122–131. [Google Scholar] [CrossRef]
- Li, F.; Chen, B.; Han, Y.; Cao, Y.; Hong, X.; Xu, M. Enhanced adsorption of caprolactam on phenols-modified Amberlite XAD16. Reactve Funct. Polym. 2021, 161, 104850. [Google Scholar] [CrossRef]
- Casadey, R.; Challier, C.; Altamirano, M.; Spesia, M.B.; Criado, S. Antioxidant and antimicrobial properties of tyrosol and derivative- compounds in the presence of vitamin B2. Assays of synergistic antioxidant e ff ect with commercial food additives. Food Chem. 2021, 335, 127576. [Google Scholar] [CrossRef]
- Yuste, S.; Ludwig, I.A.; Rubió, L.; Romero, M.; Pedret, A. In vivo biotransformation of (poly) phenols and anthocyanins of red-fleshed apple and identification of intake biomarkers. J. Funct. Foods 2019, 55, 146–155. [Google Scholar] [CrossRef]
- Ordonez, R.; Atares, L.L.; Chiralt, A. Physicochemical and antimicrobial properties of cassava starch films with ferulic or cinnamic acid. LWT 2021, 144, 111242. [Google Scholar] [CrossRef]
- Calder, M.; Iztapalapa, U. Food Science and Technology Optimization of the antioxidant and antimicrobial response of the combined effect of nisin and avocado byproducts. LWT 2016, 65, 46–52. [Google Scholar]
- Pastoriza, S.; Ru, A.; Jim, A. Food Science and Technology Revalorization of coffee by-products. Prebiotic, antimicrobial and antioxidant properties. LWT 2015, 61, 12–18. [Google Scholar]
- Bouarab-Chibane, L.; Forquet, V.; Lantéri, P.; Clément, Y.; Léonard-Akkari, L.; Oulahal, N.; Degraeve, P.; Bordes, C. Antibacterial properties of polyphenols: Characterization and QSAR (Quantitative structure-activity relationship) models. Front. Microbiol. 2019, 10, 829. [Google Scholar] [CrossRef]
- Gomes, F.; Martins, N.; Barros, L.; Rodrigues, M.E.; Oliveira, M.B.P.; Henriques, M.; Ferreira, I.C. Industrial Crops & Products Plant phenolic extracts as an e ff ective strategy to control Staphylococcus aureus, the dairy industry pathogen. Ind. Crops Prod. 2018, 112, 515–520. [Google Scholar]
- Monente, C.; Bravo, J.; Vitas, A.I.; Arbillaga, L.; De Peña, M.P.; Cid, C. Coffee and spent coffee extracts protect against cell mutagens and inhibit growth of food-borne pathogen microorganisms. J. Funct. Foods. 2015, 12, 365–374. [Google Scholar] [CrossRef]
- Diarra, M.S.; Hassan, Y.I.; Block, G.S.; Drover, J.C.G.; Delaquis, P.; Oomah, B.D. Antibacterial activities of a polyphenolic-rich extract prepared from American cranberry (Vaccinium macrocarpon) fruit pomace against Listeria spp. LWT 2020, 123, 109056. [Google Scholar] [CrossRef]
- Zaidan, M.R.; Rain, A.N.; Badrul, A.R.; Adlin, A.; Norazah, A.; Zakiah, I. In vitro screening of five local medicinal plants for antibacterial activity using disc diffusion method. Trop. Biomed. 2005, 22, 165–170. [Google Scholar] [PubMed]
- Azi, F.; Li, Z.; Xu, P.; Dong, M. Transcriptomic analysis reveals the antibacterial mechanism of phenolic compounds from kefir fermented soy whey against Escherichia coli 0157: H7 and Listeria monocytogenes. Int. J. Food Microbiol. 2022, 383, 109953. [Google Scholar] [CrossRef] [PubMed]
- Ren, X.; An, P.; Zhai, X.; Wang, S.; Kong, Q. Food Science and Technology The antibacterial mechanism of pterostilbene derived from xinjiang wine grape: A novel apoptosis inducer in Staphyloccocus aureus and Escherichia coli. LWT 2018, 101, 100–106. [Google Scholar] [CrossRef]

| Independent Variables | Nomenclature | Levels | ||
|---|---|---|---|---|
| Low (−1) | Medium (0) | High (1) | ||
| Solid–liquid ratio (g/mL) | X1 | 25 | 90 | 155 |
| Ethanol concentration (%) | X2 | 10 | 50 | 90 |
| Extraction cycle (No) | X3 | 2 | 3 | 4 |
| Run | Experimental Results | Predicted Results |
|---|---|---|
| 1 | 14.262 ± 1.57 | 11.718 |
| 2 | 9.580 ± 0.45 | 6.988 |
| 3 | 12.17 ± 1.52 | 11.996 |
| 4 | 9.346 ± 1.94 | 9.458 |
| 5 | 7.239 ± 1.97 | 6.347 |
| 6 | 9.290 ± 1.11 | 10.098 |
| 7 | 6.183 ± 0.83 | 5.689 |
| 8 | 10.06 ± 1.51 | 9.512 |
| 9 | 9.604 ± 2.28 | 9.512 |
| 10 | 6.069 ± 1.12 | 5.327 |
| 11 | 4.289 ± 0.81 | 5.049 |
| 12 | 10.081 ± 0.14 | 12.358 |
| 13 | 8.865 ± 2.67 | 9.512 |
| 14 | 1.741 ± 0.39 | 2.216 |
| 15 | 8.440 ± 3.04 | 8.885 |
| Factor | DF | SS | MC | F-Value | p-Value |
|---|---|---|---|---|---|
| X1 | 1 | 19.356 | 19.355 | 10.83 | 0.022 |
| X2 | 1 | 88.953 | 88.953 | 49.75 | 0.001 |
| X3 | 1 | 0.820 | 0.820 | 0.46 | 0.528 |
| X1 × X1 | 1 | 7.696 | 7.696 | 4.30 | 0.093 |
| X2 × X2 | 1 | 3.423 | 3.423 | 1.91 | 0.225 |
| X3 × X3 | 1 | 0.087 | 0.088 | 0.05 | 0.834 |
| X1:X2 | 1 | 0.088 | 0.088 | 0.05 | 0.834 |
| X1:X3 | 1 | 6.152 | 6.152 | 3.44 | 0.123 |
| X2:X3 | 1 | 9.226 | 9.226 | 5.16 | 0.072 |
| Lack of fit | 3 | 8.204 | 2.735 | 7.43 | 0.121 |
| R2 | 0.938 | ||||
| R2 adj | 0.826 |
Disclaimer/Publisher’s Note: The statements, opinions and data contained in all publications are solely those of the individual author(s) and contributor(s) and not of MDPI and/or the editor(s). MDPI and/or the editor(s) disclaim responsibility for any injury to people or property resulting from any ideas, methods, instructions or products referred to in the content. |
© 2023 by the authors. Licensee MDPI, Basel, Switzerland. This article is an open access article distributed under the terms and conditions of the Creative Commons Attribution (CC BY) license (https://creativecommons.org/licenses/by/4.0/).
Share and Cite
Paz-Arteaga, S.L.; Cadena-Chamorro, E.; Serna-Cock, L.; Torres-Castañeda, H.; Pabón-Rodríguez, O.V.; Agudelo-Morales, C.E.; Ramírez-Guzmán, N.; Ascacio-Valdés, J.A.; Aguilar, C.N.; Torres-León, C. Dual Emerging Applications of Solid-State Fermentation (SSF) with Aspergillus niger and Ultrasonic-Assisted Extraction (UAE) for the Obtention of Antimicrobial Polyphenols from Pineapple Waste. Fermentation 2023, 9, 706. https://doi.org/10.3390/fermentation9080706
Paz-Arteaga SL, Cadena-Chamorro E, Serna-Cock L, Torres-Castañeda H, Pabón-Rodríguez OV, Agudelo-Morales CE, Ramírez-Guzmán N, Ascacio-Valdés JA, Aguilar CN, Torres-León C. Dual Emerging Applications of Solid-State Fermentation (SSF) with Aspergillus niger and Ultrasonic-Assisted Extraction (UAE) for the Obtention of Antimicrobial Polyphenols from Pineapple Waste. Fermentation. 2023; 9(8):706. https://doi.org/10.3390/fermentation9080706
Chicago/Turabian StylePaz-Arteaga, Sarah L., Edith Cadena-Chamorro, Liliana Serna-Cock, Harlen Torres-Castañeda, Omar V. Pabón-Rodríguez, Carlos E. Agudelo-Morales, Nathiely Ramírez-Guzmán, Juan A. Ascacio-Valdés, Cristóbal N. Aguilar, and Cristian Torres-León. 2023. "Dual Emerging Applications of Solid-State Fermentation (SSF) with Aspergillus niger and Ultrasonic-Assisted Extraction (UAE) for the Obtention of Antimicrobial Polyphenols from Pineapple Waste" Fermentation 9, no. 8: 706. https://doi.org/10.3390/fermentation9080706
APA StylePaz-Arteaga, S. L., Cadena-Chamorro, E., Serna-Cock, L., Torres-Castañeda, H., Pabón-Rodríguez, O. V., Agudelo-Morales, C. E., Ramírez-Guzmán, N., Ascacio-Valdés, J. A., Aguilar, C. N., & Torres-León, C. (2023). Dual Emerging Applications of Solid-State Fermentation (SSF) with Aspergillus niger and Ultrasonic-Assisted Extraction (UAE) for the Obtention of Antimicrobial Polyphenols from Pineapple Waste. Fermentation, 9(8), 706. https://doi.org/10.3390/fermentation9080706

